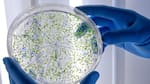
Alerta sanitaria por cianobacterias: en qué zona de Buenos Aires aparecieron y qué riesgos representan para la salud

Estafa y detención: creó una página web bancaria falsa y robó un millón de pesos
El imputado fue identificado por la Policía como Alfredo Ignacio Vicente Cazorla, a quien le secuestraron gran material con el que realizaba las estafas.

Estafa y detención en La Plata. Un hombre terminó apresado en la ciudad bonaerense de La Plata, acusado de cometer estafas reiteradas a través de una página web bancaria falsa que creó para apoderarse del dinero que las víctimas tenían en sus cuentas y por cifras cercanas a un millón de pesos.
El imputado fue identificado por la Policía como Alfredo Ignacio Vicente Cazorla, a quien le secuestraron un celular, cinco tarjetas bancarias, tres notebooks, cuatro tablets, una computadora de escritorio y un soporte de memoria.
Cómo cayó el detenido
Según explicaron fuentes a Télam, la detención se llevó a cabo luego de una serie de denuncias de personas que referían que ingresaban a la supuesta página web de su banco y con su usuario y clave a su cuenta, pero que a los poco días eran vaciadas por un valor cercano al millón de pesos.

Momento en que Cazorla es escoltado a la comisaría. Foto: captura video
A través del análisis de las cuentas bancarias de los denunciantes, los pesquisas determinaron que la página web bancaria era falsa y que la misma aparentemente había sido confeccionada por Cazorla, detallaron los voceros.
El detenido quedó a disposición del fiscal Gonzalo Petit Bosnic, de la Unidad Funcional de Instrucción (UFI) 3 platense y del juez de Garantías Nicolás Raele, al tiempo que se investiga contó con aglún cómplice.